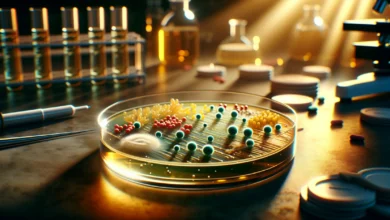
Cosa sono i batteri resistenti agli antibiotici?

Alimentazione
1 minuto fa
Cosa sono i lipidi?
Tecnologia
1 giorno fa
Come funziona il radar?
Chimica
3 giorni fa
Perché l’olio non si mescola con l’acqua?
Biologia
5 giorni fa
Perché il sangue ha gruppi diversi?
Biologia
6 giorni fa
Come funziona la retina dell’occhio?
Chimica
7 giorni fa
Perché il sale conserva gli alimenti?
Alimentazione
1 settimana fa
Cos’è una dieta equilibrata?
Tecnologia
Febbraio 5, 2026